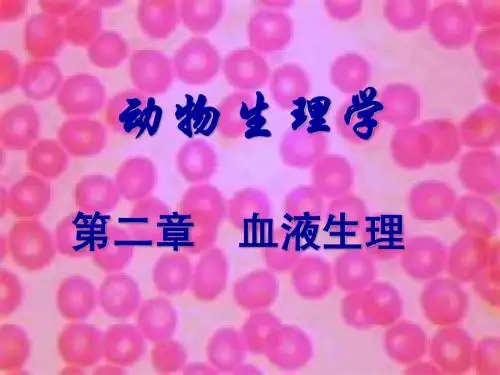

blood动物生理学
- 格式:ppt
- 大小:4.61 MB
- 文档页数:7

---------------------------------------------------------------最新资料推荐------------------------------------------------------1 / 3动物生理学4血液第四章 血液 学习目标掌握 血浆的组成与生理机能 血细胞生理血液凝固与抗凝 血型 了解 血液的理化特性 输血 第四章 血液 本章主要内容 第一节 血液概述;第二节 血浆的组成与理化特性; 第三节 血细胞生理; 第四节 血液凝固、血纤维溶解与抗凝系统; 第五节 血型与输血 第一节 血液概述 一、体液(body fluid )与血液(blood ) 1 、体液进化及其意义 多细胞动物:单细胞动物直接与环境进行交换,多细胞动物出现细胞外液,最初的细胞外液是由海水形成; 血液循环系统:细胞外液分化为血浆和组织间隙液,组织间隙液仍然是盐溶液;淋巴液和脑脊液:血管内液体溶入了多种蛋白质,出现各种血细胞,形成了血液。
第一节 血液概述 2 、内环境(internal environment ) 体液:细胞外液和细胞内液总称,约占机体总重量的60% 。
细胞内液 :存在于细胞内部的液体,是细胞内进行各种生物化学反应场所。
占人体重约40-45 %(约占体液的62 %)。
细胞外液 (内环境):组织间隙液、血浆、脑脊液、淋巴液,占人体体重的20-25 %(约占体液的38 %)。
内环境紊乱:内环境理化性质相对恒定,是机体独立生活必要条件。
第一节血液概述体液组成(将体液作为 100 %)第一节血液概述上次课内容回顾 1 、小脑对躯体运动机能调节; 2 、基底神经节对躯体运动技能的调节; 3 、大脑皮层对躯体运动机能的调节; 4 、锥体系统与锥体外系统; 5 、自主神经系统的起源与分布; 6 、自主神经系统的功能特点; 7 、体液与血液(体液、内环境、稳态)。




动物生理学名词解释生理学(physiology):是生物科学的一个分支,是研究生物机体的各种(正常)生命活动现象(机能)和机体个各组成部分的功能及其规律的一门科学。
内环境(internal environment):细胞外液被称为机体的内环境稳态(homeostasis):内环境各种物质在不断转换中达到相对平衡,即动态平衡状态,称稳态。
跨膜信号转导(transmembrane signal transduction):各种能量形式的外界信号作用于细胞时,引起细胞膜上一种或数种特异蛋白质分子的变构作用,将其信息以一种新的信号形式传递到膜内,再引起靶细胞相应功能的改变。
G-蛋白耦联受体(G protein-linked receptor):与化学信号分子(配体)特异结合的独立蛋白质分子,结合后能激活膜内的G-蛋白。
第二信使(second messenger):配体将细胞外信号带到了受体,被称作第一信使(first messenger)。
相对第一信使而言,细胞内能将配体带来的信息传递到细胞内的其它效应器的物质叫第二信使。
极化状态(polarization): (-70mv):静息时细胞膜内负外正的状态。
去极化(depolarization):(-70mv~0mv):极化现象减弱时的状态或过程。
阈电位(threshold potential,TP):膜去极化达到某一临界值时,会诱发AP的发生,这一临界值叫阈电位。
局部电位(local potential):阈下刺激不能引起膜去极化达到阈电位水平,不能形成再生性去极化,只在受刺激部位出现的一个较小去极化电位,称为局部的去极化电位,称局部电位。
突触(synapse):指一个神经元的轴突末梢与另一个神经元的胞体或突起相接触的部位。
神经递质(neurotransmitterNT):由突触前神经元合成并在其末梢释放,经突触间隙扩散到突触后膜,特异性的作用于突触后膜神经元或效应器细胞的受体,导致信息从突触前传递到突触后的一些化学物质。




动物生理学4血液动物生理学:血液血液,作为动物体内重要的生理液体之一,承担着多种重要的功能。
它由血浆和血细胞组成,可以在动物体内循环运输氧气、营养物质和代谢废物,调节体温和酸碱平衡,并参与免疫和凝血等生理过程。
本文将对动物血液的组成、功能和生理调节等方面进行详细介绍。
首先,我们先来看血液的组成。
血液由血浆和血细胞两部分组成,其中血浆是血液的液体基质,占据血液总体积的55%左右,主要包括水、蛋白质、糖类和脂类等成分。
血细胞又分为红细胞、白细胞和血小板三种,红细胞负责携氧,白细胞参与免疫和抗炎过程,血小板则主要参与血液凝固的过程。
血液的主要功能之一是运输氧气和营养物质。
红细胞携带的血红蛋白能与氧气结合,在肺部从气体中将氧气吸收,并在全身循环中将氧气输送至组织和细胞,供其进行有氧呼吸。
同时,血液中的营养物质如葡萄糖、脂肪酸、氨基酸等也可以被吸收并运输至细胞,供能和合成新的物质。
血液还能够帮助维持体温和酸碱平衡。
血液循环能够将体温分布到全身,使得机体各部位保持适宜的温度范围。
同时,血液还可以通过碳酸氢盐体系调节细胞外液的酸碱平衡,保持血液pH值的稳定,维持正常的生理功能。
此外,血液也参与免疫和凝血过程。
白细胞是机体的免疫细胞,能够识别和攻击入侵的病原体,维护机体免受感染。
血小板则可在血液受伤时迅速聚集,形成血栓,阻止血液的流失。
凝血过程中的一系列反应依赖于血浆中的凝血因子,形成凝血酶,最终使伤口形成坚实的血栓,帮助伤口愈合。
血液的生理调节具有相当的复杂性。
例如,当体内发生出血状况时,机体会通过肾上腺素、血小板激活因子和其他途径激发血液凝固的过程,起到止血的作用。
另外,在高温或剧烈运动等情况下,机体会通过扩张毛细血管调节血液的流通量,以防止体温过高和体力透支。
总结起来,血液作为动物体内重要的生理液体,承担着多种重要的功能。
它不仅能够运输氧气和营养物质,维持机体的基本代谢需要,还能够调节体温和酸碱平衡,参与免疫和凝血过程等。